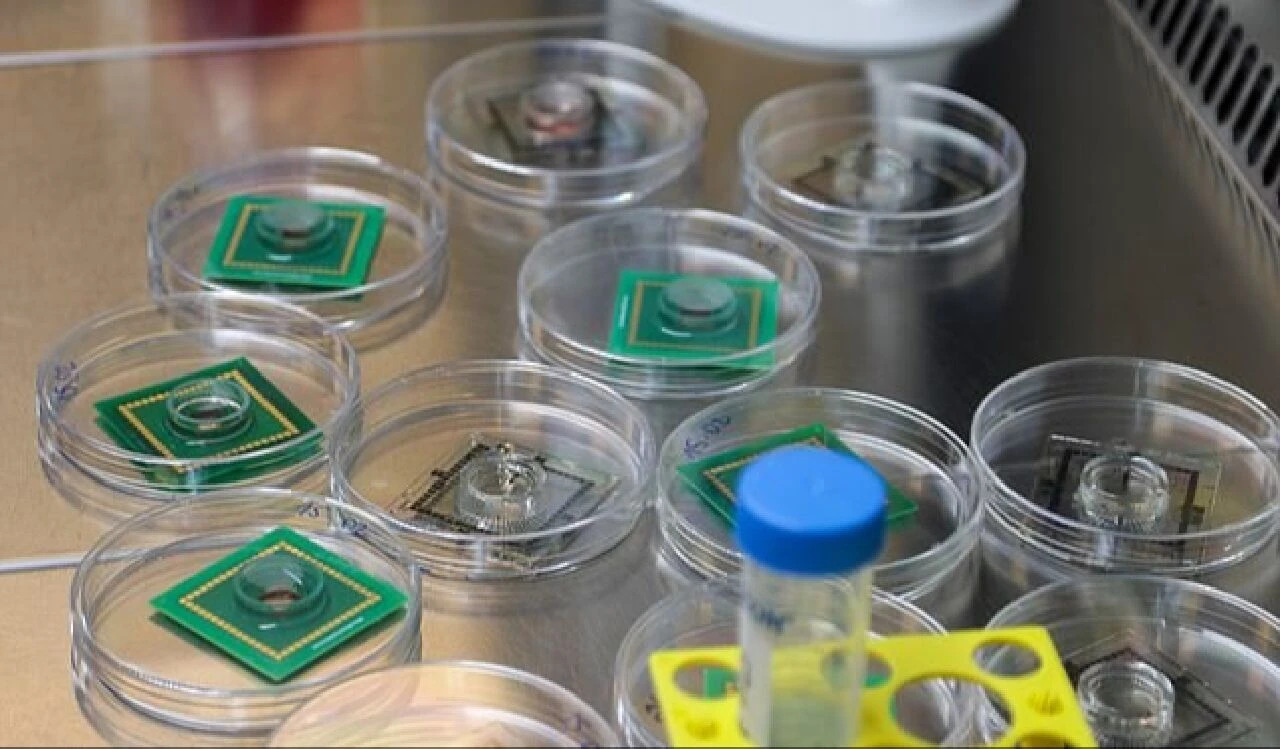
Araştırmacılar, insan beyninden 'canlı bilgisayar' üretti! 'Bilim kurgu gerçeğe dönüşüyor' - 2. Resim

Kategoriler
UYGULAMALAR
İstanbul

Robotların insanların yerini alması konusunda çok fazla korku olsa da İsveçli bilim insanları insan beyin dokusundan dünyanın ilk "canlı bilgisayarını" geliştirdi.
Bu bilgisayar 16 organoidden (laboratuarda yetiştirilen ve birbirleri arasında bilgi gönderen beyin hücresi kümeleri) oluşuyor. Geleneksel bir bilgisayar çipi gibi çalışıyorlar, yani devreler gibi hareket eden nöronları aracılığıyla sinyal gönderiyor ve alıyorlar.
Ancak bu cihazı özel kılan, daha az enerji kullanması. Çünkü "canlı nöronlar" şu anda kullanılan mevcut dijital işlemcilerden bir milyon kat daha az enerji kullanıyor.

Bilim insanları, Hewlett Packard Enterprise Frontier gibi dünyanın en iyi bilgisayarlarıyla karşılaştırıldığında, aynı hız ve 1000 kat daha fazla bellek için insan beyninin, 21 megawatt kullanan bilgisayarla karşılaştırıldığında 10 ila 20 watt kullandığını buldu.
"Canlı bilgisayar", biyolojik sinir ağlarıyla çözümler üretmeye odaklanan FinalSparks'taki bilim insanları tarafından geliştirildi.
FinalSparks'ın mini beyinleri, yaklaşık 0,5 mm çapında tahminen 10 bin canlı nörondan inşa edildi. Organoidler dopamin dozlarıyla eğitiliyor, yani görevleri doğru bir şekilde yerine getirdiklerinde ödül olarak bir kimyasal akışı alıyorlar.
Bilim insanları dopamini, insan beyninde belirli bir bölge aktive edildiğinde salınmasına benzer şekilde, beyin organoidinin belirli bir bölgesini ışığa maruz bırakarak uyguluyor.
Mini beyinler, organoidlerdeki aktiviteyi ölçen sekiz elektrotla çevrili olup, araştırmacılar nöronu etkilemek için elektrottan akım gönderebiliyorlar. Bu elektrotlar organoidleri uyarmak ve işledikleri verileri kaydetmek gibi ikili bir rol üstleniyor.
Biyolojik sinir ağlarıyla çözümler üretmeye odaklanan FinalSpark'ın eş CEO'su Dr. Fred Jordan, DailyMail.com'a, "Bu fikir bilim kurguda yaygındır, ancak bu konuda çok fazla gerçek araştırma yapılmamıştır." dedi.
Organoidler ayrıca, küçük miktarlarda sıvılar için mini bir tesisat sistemi görevi gören, hücrelere besin sağlayan ve onları canlı tutmak için gerekli besinleri sağlayan mikroakışkan bir inkübatörde barındırılıyor.
İnkübatör organoidleri vücut sıcaklığında tutuyor ve hücresel ortamın akışını ve bakımını otomatikleştirerek bakteri ve virüslerden arınmış istikrarlı bir ortam sağlıyor.
"Canlı bilgisayar"daki hücreler, 3 boyutlu organoid yapıda bir araya toplanarak 100 gün içinde yaşıyor ve ölüyor. Ancak gerçek insan beynindekilere benzerler ve benzer elektriksel aktiviteye sahip oldukları belirtiliyor.